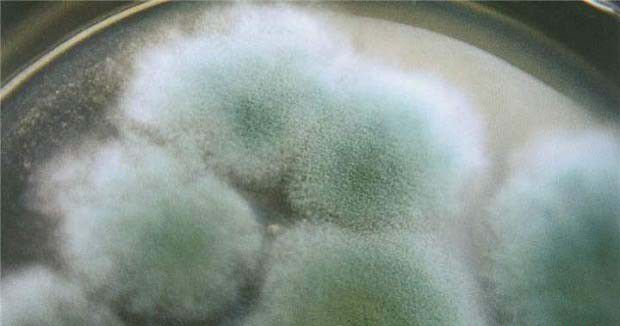
种植灵芝如何防治木霉?

种植技术
-
裂褶菌、多孔菌类是灵芝段木栽培的常见杂菌。近期有种植灵芝的网友咨询:裂褶菌、多孔菌类对灵芝有哪些危害,裂褶菌、多孔菌类感染后有哪些症状?裂褶菌、多孔菌类发生的原因是什么,哪些因素会引起裂褶菌、多孔菌类发生?种植灵芝如何预防裂褶菌、多孔菌类发生?以下想种菜网就作简单介绍,供网友们参考。裂褶菌、多孔菌类...阅读详情
-
粘菌的分布是世界性的,在有植物或植物残体而且温度适宜的地方都可存在,常常出现在灵芝栽培基质中,严重影响灵芝产量和品质。近期有网友咨询想种菜:粘菌对灵芝有哪些危害,粘菌长怎么样?种植灵芝发生粘菌的原因是什么,哪些因素会造成粘菌暴发?种植灵芝如何如何预防粘菌发生,灵芝粘菌用什么农药可以防治?以下想种菜网...阅读详情
-
黄曲霉、黑曲霉和灰绿曲霉是侵染灵芝的常见曲霉品种,近期有种植灵芝的网友咨询:黄曲霉对灵芝种植有哪些危害?黄曲霉菌长怎么样,黄曲霉菌适宜的生长条件是怎么样?种植灵芝如何防治黄曲霉,种植灵芝发现有黄曲霉怎么办?以下想种菜网就作简单介绍,供网友们参考。黄曲霉对灵芝的危害黄曲霉感染菌木,初时略带黄色,随着菌...阅读详情
-
灵芝毛霉是由毛霉真菌引起的一种常见疾病,毛霉俗称长毛霉,是一种常见的菌种污染杂菌,其生长速度快,发生普遍,喜高温、高湿。温度高、湿度大的情况下,通气不良时发生率很高,近期有种植灵芝的网友咨询:毛霉对灵芝有哪些危害,毛霉长怎么样?灵芝栽培过程中出现毛霉的原因是什么?种植灵芝如何预防毛霉发生,灵芝栽培中...阅读详情
-
根霉,又称黑色面包霉,是一种常见的侵害灵芝的杂菌,主要是黑根霉。近期有种植灵芝的网友咨询:根霉对灵芝生产有哪些危害,根霉主要有哪些特征?灵芝根霉发生原因是什么,种植灵芝如何预防根霉的发生?栽培灵芝发生根霉后怎么办?以下想种菜网就作简单介绍,供网友们参考。根霉对灵芝的危害菌种扩繁及袋栽时常易发生。培养...阅读详情
-
链孢霉,又叫脉孢霉、红色面包霉和红霉菌,是夏季生产时常见且危害严重的一种杂菌,具有生长速度快、传染性强等特点。近期有种植灵芝的网友咨询:链孢霉对灵芝有哪些影响,链孢霉有哪些特征?灵芝基质链孢霉发生原因是什么?种植灵芝如何预防链孢霉发生,灵芝发生链孢霉后如何补救?以下想种菜网就作简单介绍,供网友们参考...阅读详情
-
木霉,也称绿霉,是灵芝代料和段木栽培的主要病害之一,其危害程度和范围极大。近期有种植灵芝的网友咨询:木霉对灵芝有哪些危害,木霉菌有哪些特征?木霉菌有哪些特点,灵芝木霉发生原因是什么?种植灵芝如何防治木霉,灵芝发生木霉后如何防治?以下想种菜网就作简单介绍,供网友们参考。木霉对灵芝的危害木霉种类很多,常...阅读详情
-
鼠妇(Porcllio laevis)俗称西瓜虫、湿虫、地乌龟、鞋底虫等。属甲壳纲,等足目小动物。近期有种植灵芝的网友咨询:种植栽培灵芝时发现有鼠妇,鼠妇对灵芝有没什么危害?鼠妇有哪些特征,鼠妇长怎么样?种植灵芝如何防治鼠妇危害?以下想种菜网就作简单介绍,供网友们参考。鼠妇对灵芝的危害鼠妇主要破坏培...阅读详情
-
灰蜗牛(Fruticicola ravada Benson)属软体动物门,腹足纲,柄眼目,蜗牛科,在灵芝种植中常受灰蜗牛危害,近期有种植灵芝的网友咨询:灰蜗牛对灵芝有哪些危害,灵芝受灰蜗牛危害后有哪些症状?灰蜗牛长怎么样,灰蜗牛的发生规律是怎么样?种植灵芝如何防治灰蜗牛,灵芝灰蜗牛用什么农药可以防治...阅读详情